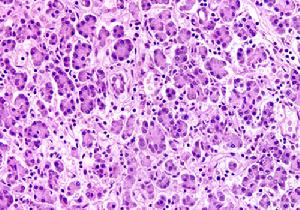
胰腺膿腫

症狀體徵
 胰腺膿腫
胰腺膿腫 胰腺膿腫
胰腺膿腫流行病學
在胰腺膿腫中,約48%膿腫累及胰腺頭部,28%累及體尾部,24%累及全胰。約於33%~40%的病例膿腫侵及小網膜囊,累及腸系膜根部以下的後腹膜腔和結腸旁溝內者占35%~43%。膿腫約發生於2%~9%的急性胰腺炎病例,其次是膽道手術、胃和胰手術、脾切除、腎上腺切除,在上述手術中,如損傷胰管系統或十二指腸或十二指腸壺腹,則可發生手術後胰腺炎和胰腺膿腫。手術後胰腺膿腫合併下膿腫有34%。
病因及生理
胰腺膿腫
胰腺膿腫胰腺膿腫是壞死性胰腺炎或胰腺周圍脂肪發生局灶性壞死、液化,繼發感染而形成,因為壞死是細菌生長的理想場所,是膿液在胰腺內或胰腺周圍的積存,內含少量或不含胰腺壞死組織,外有纖維壁包裹。
病理生理
為了明確感染和膿腫的差異,RainerIsenmann等鑑別了胰腺膿腫和感染性胰腺壞死(表1)。

1982~1993年有1300例胰腺炎患者入院,有31例(2.4%)有一個或多個膿腫,有感染性胰腺壞死的77例(5.9%)(表2)。

另外根據臨床的數據表明酒精性胰腺炎與膿腫有一個低的相關性,而手術後或胰腺損傷後有高的危險性。
診斷檢查
 胰腺膿腫
胰腺膿腫診斷:B超和CT檢查是確定診斷的主要手段。B型超聲檢查可顯示胰腺膿腫的有無、大小、數目和位置。CT引導下經皮穿刺抽吸胰腺膿液不僅可以證實診斷,而且抽吸的膿液作革蘭染色和培養,感染的細菌常為革蘭陰性桿菌,如大腸埃希桿菌、假單胞菌、克雷白桿菌和變形桿菌。某些陽性細菌可能存在,如金黃色葡萄球菌和某些厭養菌,也可以幾種細菌混雜感染。二者的結合可導致一個精確的診斷,診斷的正確率達90%~95%。因此,有膿液存在,含少量或不含胰腺壞死組織,細菌或真菌培養陽性是診斷胰腺膿腫的要點,可區別於感染性胰腺壞死。
鑑別診斷
1.胰腺假性囊腫凡急性胰腺炎、復發性胰腺炎或上腹部外傷後數天至數月,上腹部出現逐漸增大的無痛性或鈍痛性腫物,腫塊邊界多清楚,無發熱,無膿毒血症,血象多無變化,B超和CT檢查為邊界清楚的囊性腫塊。
2.慢性胰腺炎腫塊為急性胰腺炎後期或慢性胰腺炎的併發症,上腹部輕微疼痛及低熱,無膿毒血症,上腹部可觸及邊界不清的腫塊,B超和CT檢查為實性腫塊,經保守治療可愈。
實驗室檢查:白細胞計數顯著增高,常達(20~50)×109/L,血培養可有細菌生長,血清及尿澱粉酶呈持續升高,可持續1周以上。
其他輔助檢查:
1.CT檢查CT片中顯示液體的積聚,特別是積聚液體中存在氣體是膿腫形成的病理特徵,膿腫中存在氣體是主要的標誌。
2.B型超聲檢查B型超聲檢查可顯示胰腺膿腫的有無、大小、數目和位置,但對嚴重急性胰腺炎有一定的限制。
3.X線胸透可見左側膈肌升高,左下肺不張,部分可有明顯的胸腔積液。
4.腹部平片胰腺區內發現多數小氣泡影,即小氣泡征或氣液腔(膿腫內產氣菌感染所致)。另外,可見橫結腸麻痹,胃腸道積氣呈類似“皂泡”樣透亮區。
5.胃腸鋇餐檢查可見胰腺區增大徵象,十二指腸環增寬,根據膿腫的不同部位和大小,胃和橫結腸有不同程度和不同方向的移位。
6.磁共振成像(MRI)可顯示胰腺增大和胰腺膿腫區血管稀疏徵象,但費用昂貴。
治療方案
 胰腺膿腫
胰腺膿腫1.內科治療內科治療是胰腺膿腫治療的基礎,積極的抗感染治療可預防菌血症和膿腫併發症的發生,當外科手術後及經皮穿刺引流亦需要積極的抗感染治療,根據病原菌體外培養,針對感染的細菌,合理選擇有效抗生素。根據藥代動力學研究,套用能夠透過血胰屏障的抗生素,如喹諾酮類藥物或三代先鋒黴素。如不能確定感染菌,一般是多種抗生素的聯合套用。其次套用強效胰抑制劑,儘可能給予全身支持治療,補充蛋白、脂肪、糖、維生素、電解質等。
2.經皮穿刺引流在超聲或CT引導下經皮穿刺膿腫,再放置導管引流,可作為胰膿腫的初期或單個膿腫積聚的治療,但經皮放置的導管較細,很難將壞死物碎屑和稠厚的膿液引流出來,常常需要放置多根引流導管,引流成功率9%~15%,故不能代替手術引流。
3.手術治療胰腺膿腫治療愈早,效果愈好。查出所有膿腫並進行徹底引流,是治療成功的先決條件。術後膿腫持續存在和復發的主要原因往往是引流不暢。通常採用手術是清創術,手術時應充分暴露整個胰腺、十二指腸和結腸後區,有時尚需檢查小腸系膜根部和後腹膜。手術方法主要為清除壞死組織,清創應徹底,儘可能將灰色的、褐色的、黑色的壞死胰腺組織予以清除,清創術後沖洗局部,在小網膜囊及清創部位放置雪茄或引流管作外引流,常常需要安置多根引流管加持續灌洗,將管縫合固定於腹壁,每天以生理鹽水和稀釋的抗生素溶液沖洗腹腔,往往需要數千毫升腹腔沖洗液,一直到灌洗液塗片細菌陰性,並做護理和監護工作,使膿腔早日閉合。Holden報告7例需要再手術的病人中有5例是由於第一次手術時未作結腸旁膿腫引流,膿腫持續存在和復發的主要原因往往是引流不暢,為此,必須強調充分暴露腹腔,包括游離結腸、十二指腸、胰頭和胰尾。Rainer等報告的1982~1993年29個胰腺膿腫病人在手術及充分引流後,平均9天后撤去引流管,住院日37天,2個死亡,病死率6.9%,和感染性胰腺壞死的病死率為20%~50%相比有較低的病死率,當然不同單位報告的病死率不一樣,這與各醫院的條件、技術有關,雖然有的單位報告膿腫的病死率低,並不意味膿腫容易治療,其實手術是非常複雜的,應當在專科醫院、由有經驗的醫生執行手術。胰膿腫病情兇險,病死率極高,如不手術,幾乎全部死亡。匯總近來國外12個作者報告的共451例胰腺膿腫患者,其中未手術治療者病死率為96.8%,而手術治療者病死率為32%。手術治療的效果在很大程度上取決於診斷是否及時,如果診斷延遲,病死率往往明顯增加。死亡原因常常是壞死部分引起的膿毒血症,其次,尚取決於病因和合併疾病。但是成功的手術,必要時可再次手術,術後引流加灌洗,積極的抗感染和支持治療,一定能治癒胰腺膿腫。
預後及預防
 胰腺膿腫
胰腺膿腫預防:本病是由急性胰腺炎壞死組織或胰腺假性囊腫繼發感染的結果,是急性胰腺炎的嚴重併發症。因此應及時確診和有效地治療急性胰腺炎,預防胰腺膿腫發生。
併發症
1.橫結腸穿孔並下消化道出血是胰腺膿腫的嚴重併發症之一,多發生於本病的急性期,其發展過程先是胰腺膿腫或假性胰腺囊腫繼發感染並發出血,最終導致結腸壞死、穿孔。其病死率在60%以上,穿孔者85%發生在橫結腸或結腸脾曲,其原因為:
(1)胰腺壞死、感染致結腸系膜血管血栓形成。
(2)胰酶消化作用。
(3)胰腺或膿腫壁的血管壞死出血致膿腫腔內壓劇增,壓迫結腸壁及炎症浸潤破壞。
(4)結腸脾曲血供自然較差,加之該段結腸毗鄰發病的胰腺。臨床上是先發生胰腺膿腫致結腸內瘺後並發出血、便血。臨床表現為高熱、腹痛加重、腹部包塊與便血。若出血較多,應及時行結腸造口,暫時轉流,引流膿腫。小的結腸瘺無出血者可經禁食、抗感染治癒。
2.腹腔內大出血由膿腫侵蝕血管,如脾動脈、胃左動脈或胃十二指腸動脈,腸系膜上靜脈等所致。
3.腹腔多發性膿腫由於胰腺膿腫沿腹膜後擴散至兩側,向上可至膈下,仍至縱隔,向下順結腸旁溝或腰大肌下至腹股溝。
4.並發瘺十二指腸瘺、空腸瘺、胃瘺、胰瘺等。
5.其他胃排空延遲;糖尿病。
